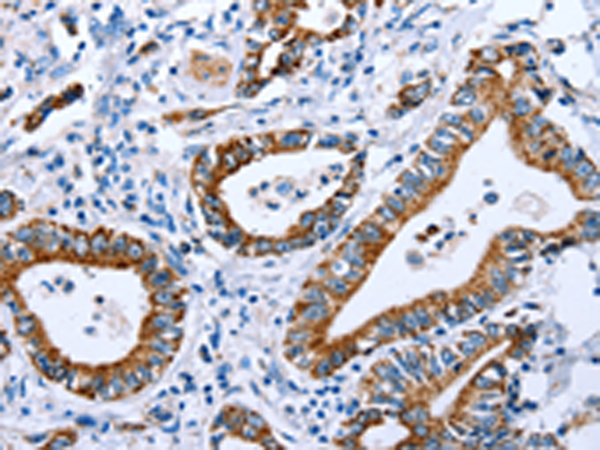

中文名稱:兔抗CPT1A多克隆抗體
|
Background: |
The mitochondrial oxidation of long-chain fatty acids is initiated by the sequential action of carnitine palmitoyltransferase I (which is located in the outer membrane and is detergent-labile) and carnitine palmitoyltransferase II (which is located in the inner membrane and is detergent-stable), together with a carnitine-acylcarnitine translocase. CPT I is the key enzyme in the carnitine-dependent transport across the mitochondrial inner membrane and its deficiency results in a decreased rate of fatty acid beta-oxidation. Alternatively spliced transcript variants encoding different isoforms have been found for this gene. |
|
Applications: |
ELISA, IHC |
|
Name of antibody: |
CPT1A |
|
Immunogen: |
Fusion protein of human CPT1A |
|
Full name: |
carnitine palmitoyltransferase 1A (liver) |
|
Synonyms: |
CPT1, CPT1-L, L-CPT1 |
|
SwissProt: |
P50416 |
|
ELISA Recommended dilution: |
1000-5000 |
|
IHC positive control: |
Human stomach cancer |
|
IHC Recommend dilution: |
25-100 |
購(gòu)物車
購(gòu)物車 幫助
幫助
 021-54845833/15800441009
021-54845833/15800441009
